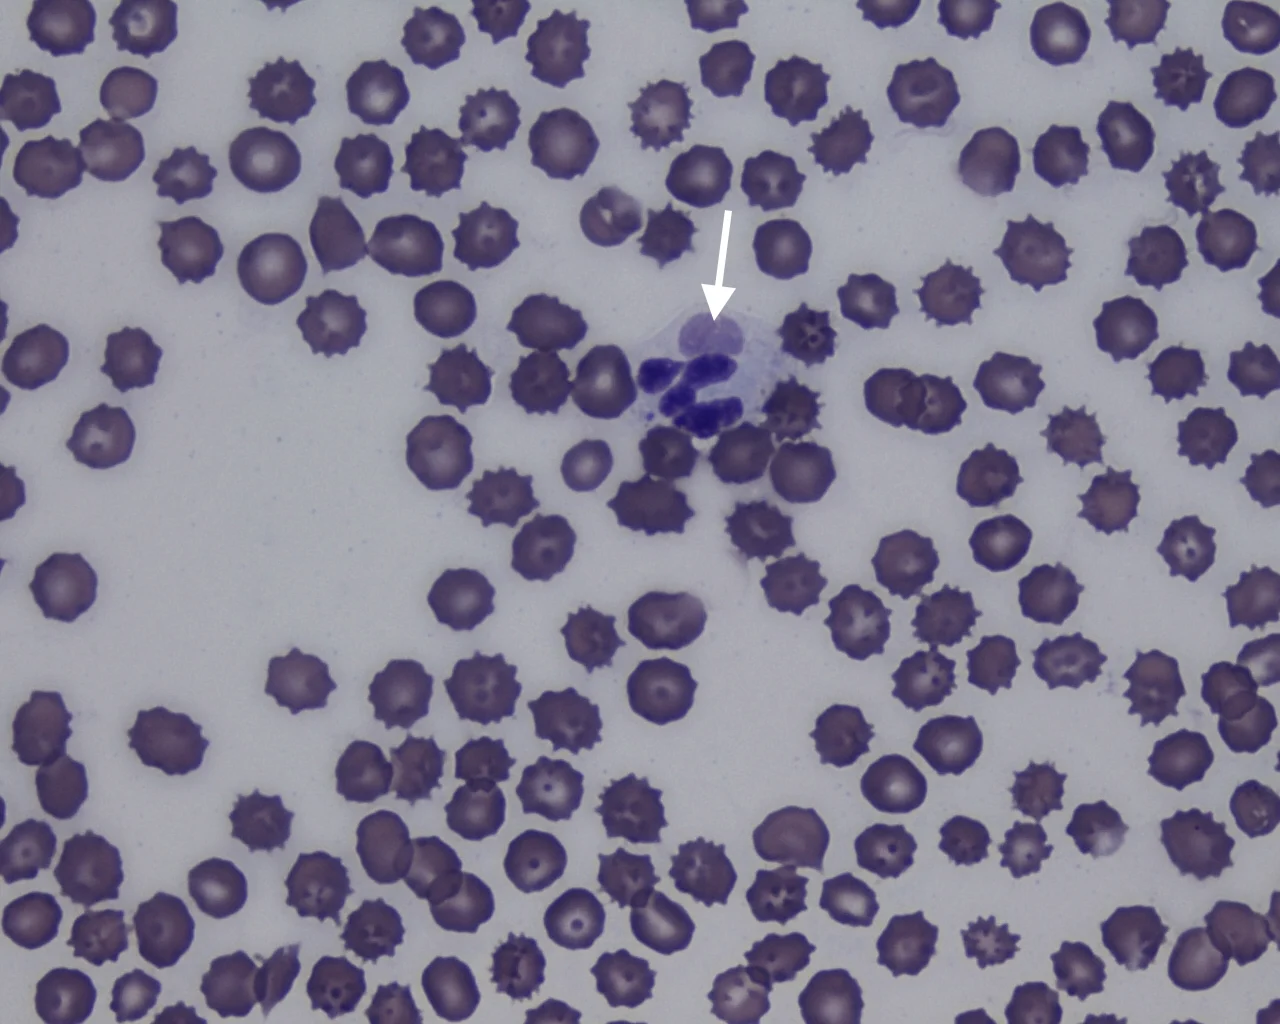

Seizures in a Young Portuguese Water Dog
John Macri, DVM, Angell Animal Medical Center, Boston, Massachusetts
Jennifer Michaels, DVM, DACVIM (Neurology), Angell Animal Medical Center, Boston, Massachusetts

Clinical History & Signalment
Poncho, a 3-month-old intact male Portuguese water dog, was presented for lethargy, anorexia, and onset of seizures. He was purchased from a breeder and received one distemper/hepatitis/parvovirus/parainfluenza vaccination at a wellness examination 3 weeks prior.
Being an excellent veterinary diagnostician depends on a solid foundation in the basics. Explore more history-taking challenges in our General Practice Skills series here.
Lethargy and hyporexia were present 4 days prior to presentation. Trembling and mouth chattering began 2 days prior to presentation and progressed to fly-biting activity and, eventually, generalized seizures (duration, 1-2 minutes), including 2 seizures the night before and 3 seizures the day of presentation. It is unknown if there were additional seizures overnight.
Physical Examination
On presentation, Poncho was actively experiencing a seizure. Levetiracetam (60 mg/kg IV once) was administered. Physical examination shortly after spontaneous cessation of the seizure revealed hyperthermia (104.6°F [40.3°C]), mildly increased lung sounds bilaterally, and a moist cough. Pulse was 148 bpm, and respiratory rate was 56 breaths per minute. Neurologic examination showed dull mentation, bilaterally absent menace response, ambulatory tetraparesis with pelvic limb proprioceptive ataxia, and postural reaction deficits in all limbs. The remainder of the physical examination was unremarkable.
Diagnosis
Differential diagnoses for seizures included infectious meningoencephalitis (eg, canine distemper virus [CDV] infection, neosporosis, toxoplasmosis, tick-borne disease [eg, Rocky Mountain spotted fever, ehrlichiosis], fungal infection [less likely]), noninfectious meningoencephalitis (eg, meningoencephalitis of unknown etiology), congenital anomalies (eg, hydrocephalus, porencephaly), hepatic encephalopathy secondary to portosystemic shunt, and toxin exposure.
CBC results showed a mild neutropenia (2,900/µL; normal, 3,300-10,100/µL), lymphopenia (500/µL; normal, 1,000-3,900/µL), and normocytic, hypochromic, nonregenerative anemia (hematocrit, 34.7%; normal, 41.7%-58.1%). Serum chemistry profile, urinalysis, and paired serum bile acid test results were unremarkable; thoracic radiographs appeared normal.
CDV real-time reverse transcription-PCR (RT-PCR) and serology (virus neutralization) results were positive (48; normal, <8). Although other infectious disease testing (eg, neospora and toxoplasma titers, tick-borne disease titers or PCR) could have been considered, CDV testing was the initial focus because of Poncho’s signalment, clinical history, concurrent neurologic and respiratory signs, and CBC findings.
Pending CDV results, brain MRI and CSF analysis were performed to evaluate for other structural causes of seizures. Brain MRI showed multifocal, asymmetric, intra-axial lesions in the left cerebrum and brainstem (Figure 1). Most likely differential diagnoses included infectious encephalopathies (eg, CDV infection) or meningoencephalitis of unknown etiology. CSF analysis was normal, and CSF distemper titer was negative (<1:4). Results likely reflected the acute stage of CDV encephalitis, during which CNS lesions are primarily characterized by direct viral replication and cellular injury leading to noninflammatory demyelinating lesions.1-3

Brain MRI of Poncho, on which a hyperintense, intra-axial lesion in the right thalamus can be seen on T2-weighted (A, arrow) and fluid-attenuated inversion recovery (B, arrow) axial images. The lesion is hypointense on the T1-weighted axial image (C, arrow). Findings suggest high fluid content common with inflammatory lesions. Postcontrast T1-weighted axial image following administration of gadolinium IV showed no contrast (D, arrow).
Diagnosis: Canine Distemper Virus Encephalitis with Suspected Pneumonia or Bronchitis
Treatment & Management
Treatment primarily focused on seizure control and supportive care. Levetiracetam (60 mg/kg IV once) was administered as initial treatment for cluster seizures. Active cooling with wet towels and fans was performed and lactated Ringer’s solution (120 mL/kg/day CRI) was administered until the patient’s temperature was <103°F (39.4°C).
Poncho was hospitalized, and levetiracetam (30 mg/kg PO every 8 hours) and lactated Ringer’s solution (120 mL/kg/day CRI) were continued. Phenobarbital (4 mg/kg IV once, then 3 mg/kg IV every 12 hours) was initiated due to continued breakthrough seizure activity, and broad-spectrum, empiric treatment for infectious and inflammatory conditions (dexamethasone sodium phosphate, 0.13 mg/kg IV every 12 hours; ampicillin/sulbactam, 50 mg/kg IV every 6 hours; clindamycin, 12.5 mg/kg IV every 12 hours) was administered, pending diagnostic test results.
TREATMENT AT A GLANCE
Vaccination is the primary method of CDV infection prevention and should be administered to puppies at 8 weeks of age, with boosters given at 12 weeks, 16 weeks, and 1 year.
Hospitalization may be needed for appropriate supportive care (eg, IV fluids, antiemetics, monitoring).
Parenteral nutrition should be provided for anorexic patients or those unable to eat due to neurologic signs, especially young patients.
Antibiotics should be considered to treat or prevent secondary infection if respiratory disease is suspected or confirmed.
Antiepileptic and hyperosmotic medications for seizure control should be administered as needed.
Short-term anti-inflammatory corticosteroids can be helpful but are controversial.
Prognosis & Outcome
Despite aggressive antiepileptic and supportive treatment, Poncho continued to have breakthrough seizures and was humanely euthanized. Postmortem evaluation was declined.
Discussion
Clinical Signs
CDV encephalitis should be a differential diagnosis for young dogs presented with neurologic signs, especially with additional systemic signs, including fever, GI signs, respiratory signs, hyperkeratosis, and conjunctivitis.1,4 CDV infection should be considered even in vaccinated patients; ≤30% of CDV cases occur in previously vaccinated dogs.4
Neurologic manifestations of CDV infection typically begin 1 to 3 weeks after systemic illness but can occur concurrently.1 Most neurologic signs are possible because of multifocal distribution of CDV in the CNS, but common signs include seizures, cerebellar and vestibular signs, ataxia, paresis, and blindness.1,4 Myoclonus (ie, sudden, repeated, involuntary contraction of a single small muscle or multiple large muscle groups; Video) is a classic sign of CDV infection and has been reported in <50% to 70% of dogs with CDV encephalitis.4-6
Transmission
Transmission can occur via body secretions but is most commonly spread by direct contact between dogs or by respiratory aerosols. Young dogs with respiratory or neurologic signs should be isolated in separate rooms or kennels. Personal protective equipment should be worn when handling these patients. CDV is a relatively labile virus that can be killed by most common disinfectants. Although CDV only survives hours to days (depending on the external environment), areas where other dogs can be exposed should be thoroughly disinfected, especially in shelter settings.1,7
Diagnosis
Antemortem diagnosis can be challenging and is often based on clinical suspicion alone.1 Lymphopenia, often present due to the ability of CDV to cause immunosuppression, can help raise the index of suspicion.1,8 Identifying intracytoplasmic inclusion bodies in RBCs and WBCs on a blood smear is pathognomonic (Figure 2). Inclusion bodies are only present in the acute phase of infection; thus, their absence does not rule out CDV infection.1,6,9
Cytoplasmic inclusion body (arrow) in a neutrophil on a blood smear. Cytoplasmic inclusion bodies in peripheral blood are transient and rare, occur only during the acute phase of CDV infection, and are a pathognomonic finding. Romanowsky-type stain, 1000× magnification
Thoracic radiographs may show an interstitial to alveolar lung pattern suggestive of bronchopneumonia.1 MRI often shows multifocal, intra-axial lesions supportive but nonspecific for CDV encephalitis, as they can be consistent with other infectious or inflammatory diseases.1,6,10
CSF can be normal or show a mononuclear or lymphocytic pleocytosis and/or elevated protein.1,6,10 Serologic examination has limited use because of high titers resulting from prior vaccination or previous subclinical or clinical infection.5 Real-time RT-PCR is the most sensitive and specific antemortem diagnostic test, but false-positive results are possible in patients that recently received a modified-live virus vaccine.1,2 Quantitative RT-PCR may be better in these patients because the result can be used to distinguish between vaccine interference and wild-type infection.1
Quantitative RT-PCR may have been preferable to confirm CDV infection in this case because the patient had been recently vaccinated; however, the positive real-time RT-PCR result was considered diagnostic based on supportive patient history, as well as clinical and other diagnostic findings.
Treatment
There is no sufficient antiviral medication protocol to treat CDV infection. Treatment should therefore focus on supportive care, which can include IV fluids and antiemetics, parenteral nutrition, antiepileptics, hyperosmotic agents (eg, hypertonic saline, mannitol), and medications for systemic disease (eg, antibiotics for secondary pneumonia, GI supportive medications), as indicated.
Seizure management in pediatric patients is generally similar to adult patients. Initial emergency stabilization can be achieved with a benzodiazepine bolus (with possible escalation to benzodiazepine CRI), ketamine bolus and/or CRI, or propofol CRI in refractory cases. Maintenance medications for pediatric use have not been well studied, but pediatric and adult seizures can usually be treated with the same anticonvulsant medications.11 Drug disposition can be different in young patients compared with adults, requiring dosage alterations; adult dosages can be administered by 3 months of age.11
Hyperosmotic agents can help reduce elevated intracranial pressure caused by inflammation and provide neuroprotective effects in patients with cluster seizures or status epilepticus; they could have been considered for this case, but the seizure stopped and the patient stabilized before they were administered.
Anti-inflammatory doses of corticosteroids can be administered to decrease inflammation and brain edema; however, use is controversial because inflammation has been associated with viral clearance.12 Long-term signs (eg, myoclonus, for which there is no established, consistently effective treatment) are possible in patients that survive the acute phase of disease.1 One case report used botulinum toxin to inhibit myoclonus.13
Preventive vaccination to decrease risk for infection is preferred for CDV management. Prognosis is variable. Severe seizures or other neurologic signs that cannot be managed result in poor to grave prognosis.
TAKE-HOME MESSAGES
CDV encephalitis should be a differential diagnosis for pediatric dogs with seizures, regardless of vaccination status.
Because transmission can occur through any bodily fluid, patients suspected to have CDV infection should be immediately isolated, and the environment should be disinfected.
Clinical signs vary, but neurologic (eg, myoclonus, ataxia, seizures) and systemic (most commonly, respiratory and GI) signs are common.
Diagnosing CDV infection can be challenging. A minimum database, thoracic radiography, PCR, antibody titers (interpreted with caution), MRI, and CSF analysis can be considered. Diagnosis can be suspected based on patient history and clinical suspicion alone.
Treatment focuses on supportive care and seizure control.
Prognosis is variable but declines considerably in patients with seizures or other neurologic signs that are difficult to control.
Prevention via vaccination reduces disease prevalence.